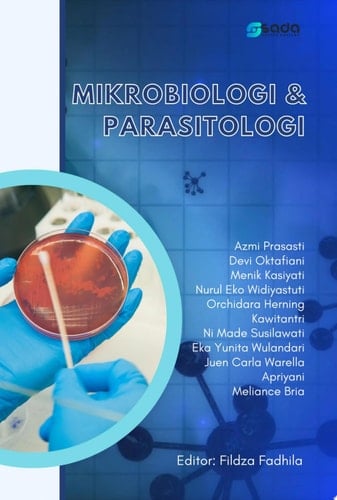
Mikrobiologi & Parasitologi

Buku ini merupakan bagian dari program bidang Mikrobiologi dan Parasitologi yang ditulis beberapa tenaga pengajar dan dikemas dalam satu topik. Penulis terdiri dari tenaga pengajar aktif di seluruh Indonesia, dan ahli pada bidang Mikrobiologi dan Parasitologi. Secara garis besar, cakupan materinya Buku ini meliputi: 1) Bentuk, Sifat dan Karakteristik Mikroorganisme. 2) Bakteriologi. 3) Virologi. 4) Konsep Pencegahan dan Pengendalian Infeksi (Sterilisasi dan Disinfeksi). 5) Nutrisi, Pertumbuhan, dan Keragaman Mikroorganisme. 6) Mikologi. 7) Pemeriksaan Mikrobiologi. 8) Konsep Pewarnaan dan Mikrobiologi. 9) Konsep Infeksi Nosokomial. 10) Entomologi. Secara umum, semua materi tersebut meliputi kajian dasar dari tema Mikrobiologi dan Parasitologi.
Page Count:
146
Publication Date:
2023-03-28
ISBN-10:
623092658X
ISBN-13:
9786230926587
No comments yet. Be the first to share your thoughts!